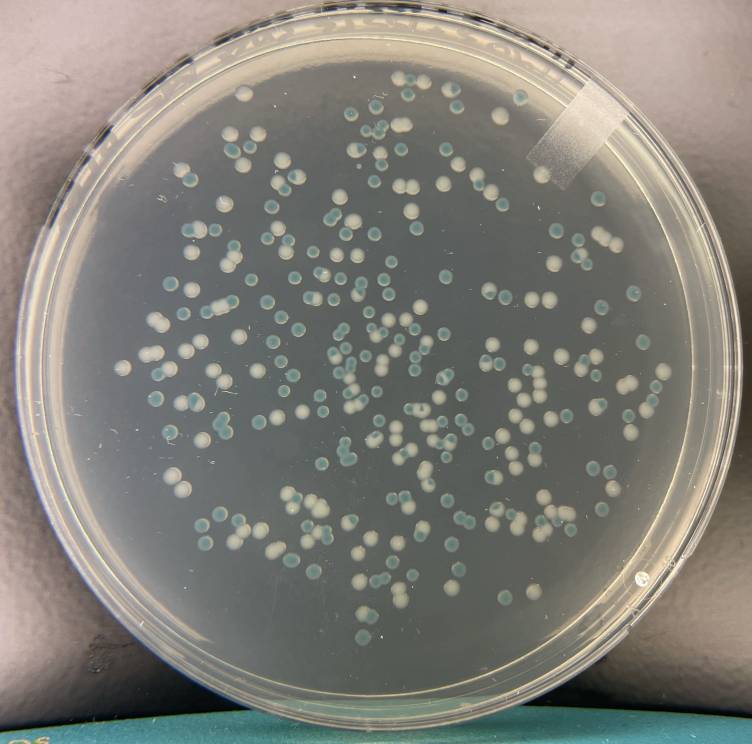
amelia rice 3

My experience in the Weil Lab this summer has been extremely rewarding. Throughout this opportunity, I got a feel for what it means to do full-time academic research, from discussing grant applications, to designing my own project, to following the paper approval process, to getting published with my name on a paper. I found that research is about having confidence, asking the right question, not knowing the answer, and then figuring out how to find it.
Over the last 14 weeks, I grew through asking these questions. Why are my experiment cultures contaminated? How can I prevent that from happening? What is the purpose of virulence testing? How can we optimize a restriction enzyme assay? Throughout, I learned numerous techniques, including DNA and RNA extraction, drip plating, mammalian cell culture, qPCR, cDNA synthesis, and much more. I learned lessons in patience, troubleshooting, and project design. My focus this summer was on the long-term evolutionary stability of a single chromosome fusion mutation in Vibrio cholerae. At several points, I noticed biofilm formation in the subcultures, indicating contamination by another microbe. When I plated the cultures, this hypothesis was confirmed; I noticed small white colonies mixed in with the normal yellowish V. cholerae. Each time, I had to go back a couple evolutionary days to a recovery culture to restart the experiment. I also had to address potential sites of contamination in creative ways so that other microbes would not infiltrate my cultures again.
This internship gave me career-applicable skills and taught me how to be a better scientist, investigator, and coworker. Thank you to the Barnard biology professors for their guidance, support, and teaching, in particular Dr. Corradino. Thank you to the Barnard Biology department for making this experience possible through Maura Shannon Barrett Internship funding. Finally, a huge thank you to my Weil Lab coworkers—Ana, Denise, Joyce, and Susan— for all their patience, mentorship, and camaraderie.